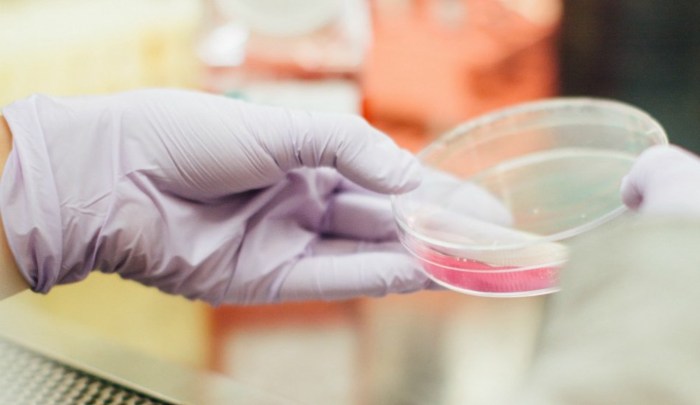

Los artículos de higiene femenina han evolucionado con el tiempo, uno de los artículos que ha tenido un cambio significativo es la toalla sanitaria, que ahora, gracias a dos mexicanas, podría ayudar a detectar enfermedades de transmisión sexual. De acuerdo con un informe del Gobierno de México del 2018, al menos el 30% de las consultas ginecológicas brindadas a mujeres en el … Continuar leyendo Mexicanas inventan toalla que detecta ETS
Categoría: Sin categoría
México, segundo lugar en número de muertes por cáncer de riñón
En México, el sobrepeso, la obesidad, el tabaquismo y los malos hábitos de salud, han traído como consecuencia el aumento de casos de cáncer de riñón. Aunque no existen datos exactos de dicho incremento, en el último año se registraron 4 mil 492 nuevos casos, por lo cual, nuestro país ocupa el tercer lugar en incidencia … Continuar leyendo México, segundo lugar en número de muertes por cáncer de riñón
Impulsan atención al cáncer en agenda pública de México
Expertos, políticos y ciudadanos participaron en un foro en México para posicionar la lucha contra el cáncer en la agenda pública del país y evitar recortes presupuestales de los fondos destinados al tema. Leticia Aguiar, coordinadora del Movimiento Latinoamericano Contra el Cáncer de Próstata, dijo a Efe que esta enfermedad aún enfrenta muchos retos en … Continuar leyendo Impulsan atención al cáncer en agenda pública de México
Diseñan nuevas herramientas para predecir la formación de cálculos renales
La litiasis en vías urinarias, o mejor conocido como piedras en los riñones, es un padecimiento bastante común. Ya que cerca del 10% de la población llega a padecer este mal. Siendo los hombres los más propensos a la formación de cálculos renales. Aunque la mayoría de las piedras son expulsadas sin mayor problema. En ocasiones se … Continuar leyendo Diseñan nuevas herramientas para predecir la formación de cálculos renales
Tipos de incontinencia urinaria en hombres y mujeres y sus consecuencias
La incontinencia urinaria se define como la pérdida involuntaria de orina. Esto implica cualquier fuga o cualquier paso del líquido a través de la vía urinaria en un momento en el que la persona no lo desea. Tanto en hombres como en mujeres se presentan dos tipos de incontinencia: la de urgencia y la de … Continuar leyendo Tipos de incontinencia urinaria en hombres y mujeres y sus consecuencias
Por qué da cistitis después de tener sexo
México.- La cistitis es un padecimiento que se caracteriza por la inflamación de la vejiga, generalmente es producto de una infección causada por bacterias, también se le conoce como infección urinaria. Esta infección puede ser causada por bacterias que entran a las vías urinarias a través del uréter y una forma habitual de la entrada … Continuar leyendo Por qué da cistitis después de tener sexo
EN MÉXICO, POR CADA MIL HABITANTES HAY 1.4 PACIENTES CON INSUFICIENCIA RENAL
La cifra es mayor a lo registrado en el plano mundialHipertensión arterial y diabetes causan 85 por ciento de los casos de este padecimiento La diabetes e hipertensión arterial son causa del 85 por ciento de todos los casos de enfermedad renal, por lo que al evitar estos padecimientos también es posible evitar la enfermedad … Continuar leyendo EN MÉXICO, POR CADA MIL HABITANTES HAY 1.4 PACIENTES CON INSUFICIENCIA RENAL
Va en aumento cirugía robótica en algunos hospitales públicos en México
La cirugía robótica se ha consolidado en algunos hospitales públicos en México como una herramienta efectiva para lograr operaciones en partes del cuerpo de difícil acceso y que requieren mayor precisión, señaló este martes un especialista. En conferencia de prensa, el doctor Alejandro Alías Melgar, urólogo especialista en cirugía robótica del Centro Médico Nacional “20 de Noviembre”, señaló … Continuar leyendo Va en aumento cirugía robótica en algunos hospitales públicos en México
Hombres más propensos a cáncer de próstata si en familia hubo cáncer de mama
Los varones con antecedentes familiares de cáncer de mama tienen el doble riesgo de padecer cáncer de próstata, señaló este lunes un experto en México. José Arturo Rodríguez Rivera, jefe del servicio de Urología del Hospital General de Occidente en la ciudad mexicana de Guadalajara, explicó que el factor genético de cáncer de mama en … Continuar leyendo Hombres más propensos a cáncer de próstata si en familia hubo cáncer de mama
Entre 60% y 70% de casos de cáncer de próstata son indoloros y asintomáticos
Entre 60 % y 70 % de los casos de cáncer de próstata no presentan dolor ni síntomas específicos, por ello es necesario el diagnóstico oportuno antes de que la enfermedad se extienda a otros órganos, señaló este lunes un especialista. El urólogo Alejandro Alías Melgar, coordinador de cirugía del Centro Médico Nacional (CMN) "20 … Continuar leyendo Entre 60% y 70% de casos de cáncer de próstata son indoloros y asintomáticos